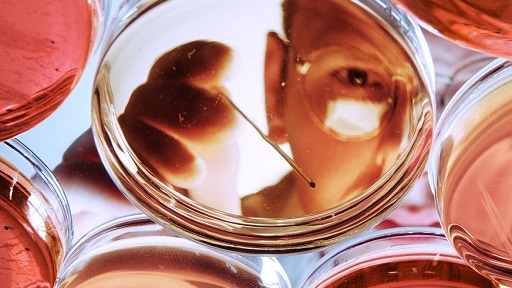
Interrogate Biology

How to… interrogate biology
Leverage the power of our biological assays to identify novel targets.
Leverage the power of our biological assays to identify novel targets.
How to… detect and measure
The use of appropriate analytics such as capillary electrophoresis, cell counters, plate readers, high-content screening systems and in vivo imaging systems can help you make informed decisions and accelerate the drug discovery process.
The use of appropriate analytics such as capillary electrophoresis, cell counters, plate readers, high-content screening systems and in vivo imaging systems can help you make informed decisions and accelerate the drug discovery process.
How to… automate and analyze
Increase the efficiency, accuracy, and precision of drug discovery workflows through our robotic liquid handlers and data management systems.
Increase the efficiency, accuracy, and precision of drug discovery workflows through our robotic liquid handlers and data management systems.